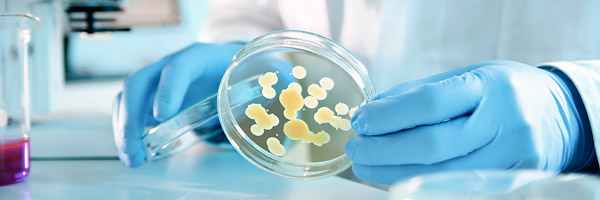
Опухолевые маркеры

Опухолевые маркеры - онкомаркеры
Добавил пользователь Евгений Кузнецов Обновлено: 12.12.2025
Онкомаркеры — это особенные специфические белки/антигены, образующиеся в крови. В норме они выделяются клетками в незначительном количестве и выполняют в организме разнообразные функции. Однако при наличии злокачественного процесса концентрация этих веществ резко возрастает – онкомаркер может выделяться как самими опухолевыми клетками, так и здоровыми тканями, окружающими новообразование.
Ценностью исследования уровня онкомаркеров является возможность обнаружить патологический процесс задолго до появления первых проявлений заболевания. Кроме того, подобный анализ нередко ставит окончательную точку в сложных диагностических ситуациях.
Анализы крови на онкомаркеры обладают высокой информативностью при соблюдении рекомендаций перед сдачей:
Различные маркеры характеризуют различные опухоли. В некоторых случаях несколько маркеров характеризуют одну и ту же форму рака, тогда для повышения достоверности результатов одновременно проводят анализ нескольких опухолевых маркеров. Также один и тот же онкомаркер может свидетельствовать о нескольких формах рака.
- ПСА или простато-специфический антиген. Вырабатывает злокачественная опухоль простаты. Нормальное содержание — до 4 нг на мл. Количество 4-10 нг на мг свидетельствует об угрозе развития рака простаты, а превышение 10 нг на мл считается патологическим.
Значительное повышение уровня ПСА в сыворотке иногда обнаруживается при гипертрофии предстательной железы, а также при воспалительных её заболеваниях. Также, следует учитывать, что пальцевое ректальное исследование, цистоскопия, колоноскопия, трансуретральная биопсия, лазерная терапия, задержка мочи могут вызвать более или менее выраженный и длительный подъём уровня ПСА. Влияние этих процедур на уровень ПСА максимально выражено на следующий день после их проведения, причём наиболее значительно — у больных с гипертрофией простаты. Исследование ПСА в таких случаях рекомендуется проводить не ранее чем через 7 дней после проведения перечисленных процедур. Уровень ПСА повышается при доброкачественных и злокачественных заболеваниях предстательной железы. При этом при карциноме простаты больше увеличивается доля связанной фракции, поэтому соотношение между свободным и общим ПСА уменьшается.
Определение содержания РЭА в сыворотке крови человека имеет диагностическое значение, и может быть использовано для мониторинга терапии, выявления рецидивов и недиагносцируемых метастазов рака различных локализаций и органной специфичности.
Определение содержания СА-125 в сыворотке крови человека может быть использовано для диагностики рака яичников и динамического контроля его уровня с целью оценки эффективности проводимой терапии, раннего выявления метастазов, а также прогнозирования течения заболевания. Неонкологическая патология: повышение уровня СА-125 в крови наблюдается при вовлечении в процесс серозных оболочек — перитоните, перикардите, плеврите разной этиологии. Более высокое увеличение уровня СА-125 в крови наблюдается иногда при различных доброкачественных гинекологических опухолях (кисты яичников), а также при воспалительных процессах, вовлекающих придатки, и доброкачественной гиперплазии эндометрия.
Уровень CА 19-9 повышается при злокачественных новообразованиях: рак поджелудочной железы; рак желчного пузыря и желчных путей; рак мочевого пузыря; первичный рак печени; рак желудка; рак прямой кишки; рак сигмовидной кишки; рак молочной железы; рак яичников; рак матки. Неонкологическая патология, которая сопровождается повышением уровня CА 19-9: цирроз печени; холецистит; муковисцидоз; гепатиты; желчекаменная болезнь.
Повышение уровня CA 15-3 наблюдается при злокачественных новообразованиях: рак молочной железы; бронхогенный рак; рак желудка; рак печени; рак поджелудочной железы; рак яичников; рак шейки матки; рак матки; рак эндометрия. Неонкологическая патология: доброкачественные заболевания молочных желез; цирроз печени; беременность в III триместре; аутоиммунные заболевания.
Важно помнить! Отклонение результатов от нормы не всегда является показателем онкологии. Уровень многих индикаторных соединений способен повышаться при воспалительных процессах, травмах органов, гормональных сбоев. В таком случае медицинским специалистом учитывается не только непосредственное повышение уровня онкомаркеров, но и степень данного увеличения, клинические симптомы, взаимосвязь с результатами других методов исследований и анализами. На основе всей этой диагностической картины и определяется причина патологических изменений.
Серологические опухолевые маркеры в вопросах и ответах
В последнее время врачи все чаще проводят исследование в крови пациентов уровня «опухолевых маркеров». Далеко не все знают, что это за анализ. Сегодня мы хотим подробнее поговорить об этом важном исследовании.
Первые попытки найти вещества - маркеры (от англ. mark–знак, метка), позволяющие диагностировать злокачественные опухоли, предпринимались еще древними врачевателями. До наших дней дошли документальные свидетельства того, как еще 2000 лет назад египтяне стремились найти маркеры для дифференциальной диагностики рака молочной железы и мастита.
Первый опухолевый маркер был описан в 1846 г. врачом Бенс-Джонсом, обнаружившим избыток особого белка в моче больной множественной миеломой. Но только в ХХ веке развитие биохимии позволило идентифицировать этот белок, который впоследствии получил название белка Бенс-Джонса.
Что такое серологические опухолевые маркеры?
Опухолевые маркеры (или «опухолеассоциированные маркеры») - это вещества, которые синтезируются опухолевыми клетками в существенно больших количествах, чем нормальными клетками. То есть опухолевые маркеры – это вещества, концентрация которых повышается в крови онкологического больного. Уровень опухолевых маркеров в крови онкологических больных часто бывает значительно выше, чем у здоровых лиц.
Какую информацию дают анализы опухолевых маркеров?
Возрастание в крови уровней опухолевых маркеров часто указывает на развитие опухолевого процесса, дает дополнительную информацию о степени его распространенности (стадии болезни) и, что особенно важно, об ответе на лечение, т.е. эффективности проведенной терапии. После окончания первичного лечения периодическое исследование опухолевых маркеров часто дает возможность заподозрить развитие рецидива опухолевого процесса раньше традиционно используемых в онкологии методов диагностики.
Для больных с какими злокачественными новообразованиями исследуют опухолевые маркеры?
Известны опухолевые маркеры рака яичников, тела и шейки матки, молочной железы, предстательной железы, органов желудочно-кишечного тракта, легкого других злокачественных новообразований.
Наиболее часто используемые серологические опухолевые маркёры
Локализация опухоли
Серологические опухолевые маркеры
Рак молочной железы
СА 15-3, РЭА, СА 19-9, НЕ4, СА 72-4 (гормоны: пролактин, эстардиол)
СА 125, НЕ4, СА 72-4, СА 19-9
Рак шейки матки
СА 125, НЕ4, СА 19-9, РЭА
СА 72-4, РЭА, СА 19-9
Рак поджелудочной железы
Рак мочевого пузыря
Tu M2-PK, SCC, СА 125, НЕ4
Рак предстательной железы
ПСАобщ, ПСАсвоб/ ПСАобщ., [-2] проПСА, индекс здоровья простаты (ИЗП), НЕ4
Cyfra 21-1, SCC, РЭА
Cyfra 21-1, SCC, РЭА
Рак щитовидной железы:
Тиреоглобулин (ТГ), антитела к ТГ, ТТГ
Метастазы в костях
Хромогранин А, 5-ГИУК, гастрин 17
Если у человека повышен тот или иной опухолевый маркер, означает ли это диагноз «рак»?
Высокие уровни одних маркеров подтверждают подозрения, других- служат основанием для дополнительного обследования, так как концентрации маркеров могут повышаться и при доброкачественных опухолях и воспалительных заболеваниях. Поэтому, если у человека содержание опухолевого маркера превышает норму, следует провести дообследование для установления причины этого и прежде всего исключить наличие злокачественной опухоли. Кроме того, рекомендуется повторить анализ через 1-1,5 месяца. В целом же интерпретацией анализов опухолевых маркеров как и результатов других диагностических методов, занимается врач, имеющий специальную подготовку.
Таким образом, повышение маркера — это не всегда злокачественный процесс, но всегда патологический процесс, который требует дообследования.
Всегда ли повышен опухолевый маркер при наличии злокачественной опухоли?
В ряде случаев у больных со злокачественными заболеваниями уровень маркеров может оставаться в пределах нормы. Это означает, что у отдельных пациентов опухолевые клетки не выделяют в кровь данный маркер, что еще раз подтверждает необходимость использования опухолевых маркеров в комплексе с другими диагностическими методами. Маркеры могут оставаться в пределах нормы и при начальных стадиях опухолевого процесса, так как объем опухоли в этих случаях мал. В то же время для опухолей каждого типа подобрано несколько опухолевых маркеров. Поэтому для многих пациентов с установленным диагнозом злокачественной опухоли удается найти маркер, уровень которого повышен до начала лечения, и использовать этот маркер для мониторинга течения болезни.
Что дает регулярное определение содержания опухолевых маркеров у онкологических больных в процессе лечения и впоследствии при наблюдении за больными?
Оценка содержания опухолевых маркеров в крови дает возможность лечащему врачу получить дополнительную информацию, позволяющую, во-первых, оценить эффективность проведенного лечения и назначить, при необходимости, иную схему терапии. Во-вторых, уровни опухолевых маркеров учитывают и при решении вопроса о прекращении или продолжении химиотерапии больных. Особо следует отметить, что при наблюдении за больными после окончания лечения опухолевые маркеры часто позволяют уловить начало возобновления болезни до ее проявления и раньше других методов диагностики.
Какие опухолевые маркеры и для каких больных наиболее широко используются сегодня?
В настоящее время одним из наиболее успешно используемых в онкологической клинике опухолевых маркеров является простат специфический антиген (ПСА) В США, например, выполняется программа обязательного ежегодного исследования ПСА у всех мужчин старше 45 лет, направленная на выявление начальных форм рака предстательной железы. В нашей стране многие врачи – урологи также назначают пациентам анализ на ПСА. Результаты анализа позволяют выделить группу мужчин для дообследования и, таким образом, выявить рак предстательной железы в ранней стадии, когда терапия приводит к полному излечению. ПСА, кроме того, успешно используется для контроля эффективности лечения как у больных раком, так и пациентов, страдающих аденомой предстательной железы. С помощью ПСА выявляют также начало возобновления заболевания, поэтому уровень этого маркера следует периодически определять у пациентов после проведенного лечения.
Поскольку ПСА может быть повышен не только при раке предстательной железы, но и при доброкачественных процессах в простате (аденома, простатит), существуют методы оценки разных фракций ПСА, что позволяет проводить дифференциальную диагностику для этих заболеваний.
Недавние зарубежные исследования показали, что при развитии рака яичников уровень СА 125 начинает расти за 2-3 года клинического проявления болезни. Поэтому сегодня СА125 остается одним из наиболее вероятных претендентов на роль маркера скринингового типа - для активного выявления рака яичников. Уровень СА 125 целесообразно измерять у женщин после 50 лет, так именно на этот период жизни приходится пик заболеваемости раком яичников.
До 80% больных раком яичников имеют повышенный уровень СА125, который значительно снижается в процессе лечения. Это позволяет использовать данный маркер для оценки эффективности лечения рака яичников. При возобновлении опухолевого процесса концентрация СА 125 в крови начинают возрастать за 2-6 мес. до его клинического проявления. На этом свойстве белка СА125 основан метод динамического наблюдения больных раком яичников с целью раннего выявления рецидивов опухоли.
В то же время необходимо знать, что уровни СА125 могут несколько повышаться при доброкачественных опухолях яичников, воспалительных заболеваниях и эндометриозе (в меньшем проценте случаев и меньшей концентрации, чем при раке яичников), что позволяет использовать данный опухолевый маркер для мониторинга пациенток с этими заболеваниями.
В последнее десятилетие в арсенале онкогинекологов появился новый опухолевый маркер рака яичников – НЕ4 (human epididymis protein 4). Повышенные уровни белка НЕ4 обнаруживаются у 88,0% больных раком яичника. При этом НЕ4 значительно реже, чем СА125, повышен у пациенток с доброкачественными гинекологическими заболеваниями и практически не повышается при эндометриозе.
Комбинация НЕ4 с СА 125 позволяет улучшить чувствительность метода дифференциальной диагностики злокачественного и доброкачественного процесса в яичниках и, по мнению ряда авторов, является более точным предиктором злокачественного процесса при наличии у женщины образований в малом тазу. Это крайне важно для выработки адекватной тактики лечения таких пациенток на этапе диагностики.
Анализ данных по сочетанному использованию двух ОМ (СА 125 и НЕ4) в дифференциальной диагностике РЯ с использованием логистической регрессии позволил разработать алгоритм ROMA (risk of ovarian malignancy algorithm). ROMА учитывает концентрации онкомаркеров НЕ4 и СА 125, а также менопаузальный статус пациентки и позволяет рассчитать вероятность рака яичников, разделяя женщин с образованиями в малом тазу на группы с высоким и низким риском данного заболевания. Было показано, что значения ROMA ≥ 27,7% и ≥ 13,1% для женщины в постменопаузе и пременопаузе, соответственно, ассоциированы с высоким риском обнаружения раком яичников.
При колоректальном раке рекомендуется определять маркеры: РЭА, СА 19-9. Показано, что уровень РЭА на старте лечения коррелирует со стадией процесса, с продолжительностью безрецидивного после первичного лчения периода, а также с прогнозом течения опухолевого процесса.
Особенно высокий уровень обнаруживается у пациентов с метастазами в кости, печень, легкие и другие органы. Падение уровня РЭА после лечения является показателем его эффективности, вторичный подъем данного маркера свидетельствует о развитии рецидива и метастазов.
СА 19-9 - маркер, который следует определять одновременно с РЭА у больных со злокачественными новообразованиями кишечника прежде всего на старте лечения, что особенно ценно для пациентов с РЭА-негативными опухолями.
Следует иметь в виду, что РЭА - белок острой фазы, поэтому уровень его может подниматься и у больных с разнообразными острыми и хроническими воспалительными заболеваниями.
Маркером для мониторинга больных фолликулярным и папиллярным раком щитовидной железы является ТГ (тиреоглобулин). ТГ – гликопротеид коллоида щитовидной железы, предшественник тиреоидных гормонов.
Содержание ТГ в крови может повышаться не только при раке щитовидной железы, но и при тиреотоксикозе, токсической аденоме и тиреоидите. Поэтому по концентрации ТГ нельзя дифференцировать заболевания щитовидной железы. Определение уровня ТГ в крови показано, прежде всего, больным до и после удаления щитовидной железы по поводу рака в качестве контроля радикальности проведенной операции. Выявление ТГ в крови у больных без щитовидной железы свидетельствует о наличии в организме ткани щитовидной железы; при прогрессировании заболевания уровень этого белка возрастает.
Необходимо отметить, что определение ТГ следует проводить не ранее чем через 3 нед после пункционной биопсии щитовидной железы и через 3 мес после удаления органа по поводу рака щитовидной железы.
Кальцитонин - это маркер медулярного РЩЖ.
Таким образом, широко используемые в настоящее время тесты на опухолевые маркеры представляют собой информативные, простые в исполнении, доступные по цене, нетравматичные методы активного выявления злокачественных новообразований и наблюдения за онкологическими больными, позволяющие осуществлять оценку эффективности лечения и доклиническое выявление рецидива заболевания. Кроме того, исследовать опухолевые маркеры весьма полезно у лиц с повышенным онкологическим риском (наличие родственников, больных раком; работники вредных производств и др.) для раннего выявления онкологических заболеваний.
Когда не рекомендуется проводить исследования опухолевых маркеров?
Не рекомендуется исследовать маркеры при острых и обострении хронических заболеваний, а также после инвазивных диагностических процедур. В этих случаях можно получить ложноположительные результаты.
Может ли человек без назначения врача сдать анализ крови для определения конкретного опухолевого маркера?
Да. Это можно сделать и в нашем институте. Но еще раз хотим подчеркнуть, что грамотно назначить анализ и интерпретировать его результаты может только врач. Поэтому лучше до сдачи крови посоветоваться с врачом для решения вопроса о выборе опухолевых маркеров, наиболее информативных для конкретного пациента. В то же время мы не исключаем возможности, в частности, для мужчин, проявлять инициативу и самостоятельно сдавать анализ ПСА, а для женщин СА125.
Опухолевые маркеры: общие положения
Опухолевые маркеры – это сложные вещества, чаще всего, глико- или липопротеиды. Опухолевые маркеры формируются внутри или на поверхности опухолевых клеток или же под действием опухоли происходит их индукция в других клетках. Таким образом, опухолевые маркеры попадают в кровеносное русло и определяются в периферической крови. Теоретически опухолевые маркеры должны продуцироваться только клетками злокачественной опухоли и не должны определяться у здоровых людей и у лиц с доброкачественными патологиями. Но в действительности не найдено ни одного маркера, специфичного только для опухоли.
Диагностическая значимость опухолевого маркера определяется тремя характеристиками:
- диагностической чувствительностью,
- диагностической специфичностью,
- дискриминационным уровнем (ДУ) или дискриминационной концентрацией (ДК).
ДУ представляет собой допустимую верхнюю границу концентрации опухолевых маркеров у здоровых людей и у пациентов с доброкачественными заболеваниями. Все значения маркера, которые превышают ДУ, считаются положительными или патологически повышенными.
Специфичность опухолевых маркеров представляет собой процентное выражение частоты истинно отрицательных результатов теста в группе здоровых индивидуумов или лиц с доброкачественными патологиями.
Чувствительность опухолевых маркеров представляет собой процентное выражение частоты истинно положительных результатов теста в группе онкологических больных.
При специфичности 95-98% чувствительность может колебаться в широких пределах – от 15% до 90% и более – для разных опухолевых маркеров и для одного и того же маркера в отношении разных патологий. Большинство циркулирующих опухолевых маркеров по причине недостаточной чувствительности и специфичности непригодно для выявления онкопатологии в бессимптомной популяции. Однако в группах повышенного риска с более высокой частотой данного заболевания использование опухолевых маркеров даёт возможность раннего выявления ряда опухолей.
Несмотря на ограниченное использование онкомаркеров в диагностике, они широко применяются в клинике. Опухолевые маркеры оказывают реальную помощь при оценке прогноза, оценке радикальности операции, мониторинге, получении дополнительной информации.
Прогноз. На момент диагноза опухоль изучают в плане прогноза заболевания. Уровни большинства опухолевых маркеров до лечения коррелируют с основными прогностическими факторами – размером опухоли, поражением лимфатических узлов, наличием или отсутствием метастазов, гистологическим типом и степенью дифференцировки опухоли и т.п. Для многих опухолевых маркеров показано их значение в качестве независимых прогностических факторов. Уровни большинства опухолевых маркеров на момент диагностирования имеют обратную зависимость с выживаемостью и длительностью безрецидивного периода.
Пациенты с высокими значениями маркера отличаются неблагоприятным прогнозом. Использование прогностических факторов и расчет прогноза приносят реальную пользу в лечении рака. Они представляют большой интерес не только для вычисления выживаемости, но также для подразделения пациентов на группы риска, где они будут получать дополнительную к оперативному лечению химиотерапию, призванную разрушить не обнаруженные при операции опухолевые образования, которые могут привести к появлению метастазов.
Для пациентов с хорошим и плохим ожидаемым прогнозом используют дифференцированные схемы лечения, которые отрабатываются в рандомизированных исследованиях. Это может позитивно отражаться на качестве жизни пациента, толерантности к терапии, эффективности лечения и рациональной экономии. По этой причине использование маркеров в качестве прогностических факторов является весьма желательным.
Оценка радикальности операции. После радикального удаления опухоли концентрация опухолевых маркеров в крови должна снижаться в соответствии с его периодом полужизни. Если скорость снижения маркера значительно ниже теоретической, то с большой долей вероятности можно предполагать наличие скрытых метастазов.
Мониторинг пациентов в ремиссии. После проведенного лечения пациент должен находиться под наблюдением онколога с обязательным регулярным определением опухолевых маркеров. При отрицательных значениях опухолевых маркеров рецидива не наблюдается. Повышение значений опухолевых маркеров с высокой степенью вероятности свидетельствует о рецидиве, клинические симптомы которого могут быть замечены лишь 3-6 месяцев спустя. Поэтому в некоторых случаях, например, при герминогенных опухолях, повышение опухолевых маркеров является достаточным основанием для начала химиотерапии, что позволяет улучшить отдалённые результаты.
Оценка эффективности лечения. Многочисленные литературные данные свидетельствуют о том, что регрессия опухоли сопровождается снижением сывороточного уровня соответствующего маркера. Отсутствие изменений или нарастание значений опухолевых маркеров даёт основание думать о резистентности опухоли к проводимой терапии и является основанием для пересмотра её тактики.
При интерпретации результатов следует учитывать множество факторов, способных влиять на сывороточный уровень опухолевых маркеров:
- наследственные,
- расовые,
- пол,
- возраст,
- физиологическое состояние,
- циркадные ритмы и суточные изменения,
- вредные привычки,
- диагностические исследования (неинвазивные и инвазивные),
- течение послеоперационного периода,
- доброкачественные патологии,
- лекарства.
Чрезвычайно важно также, каким методом определялся опухолевый маркер (и в этом контексте необходимо проводить его динамическое определение в одной и той же лаборатории). Это важно потому, что методы клинической химии определяют собственно вещество, тогда как иммунологические методы, основанные на использовании моноклональных антител, определяют отдельные эпитопы. Количество эпитопов на одной молекуле может широко варьировать у разных людей. Экспрессия эпитопов может значительно изменяться в зависимости от физических условий и структурных особенностей молекулы (например, при нагревании трудно определить сывороточный уровень СА125, но при этом может определяться активность СА199). Многие современные методы распознают отщеплённые от молекулы эпитопы, в результате чего можно получить трудно сравнимые как с клинической, так и с аналитической точек зрения результаты.
При рутинном определении опухолевых маркеров в разных лабораториях отличающиеся результаты могут быть функцией используемого метода. Например, при определении ХГЧ могут быть использованы анти-бета, анти-альфа и анти- бета/альфа антитела. В любом случае необходимо учитывать метод и факторы, которые могут вызывать ложноположительные результаты.
По материалам:
З.Г.Кадагидзе, к.б.н., В.М.Шелепова, д.м.н., профессор,
Лаборатория клинической иммунологии опухолей, РОНЦ РАМН
Определение уровня опухолевых маркеров (онкомаркеров)
Основным направлением деятельности Клинико-диагностической лаборатории является исследование содержания онкомаркеров в сыворотке крови.
Опухолевые маркеры – специфические вещества (разной химической природы), являющиеся продуктами жизнедеятельности злокачественных клеток или клеток, ассоциированных со злокачественным ростом, и обнаруживающиеся в крови и/или моче онкологических пациентов. От соединений, продуцируемых нормальными клетками, они отличаются или качественно, или количественно.
Определение опухолевых маркеров позволяет диагностировать онкологическое заболевание на ранних стадиях его формирования, позволяет осуществлять мониторинг течения заболевания, диагностика рецидивов и метастазирования опухоли.
Стоит отметить, что каждой локализации опухолевого процесса может соответствовать повышение в крови уровня одного или нескольких маркеров.
В нашем центре исследуется широкий спектр онкомаркеров:
РЭА – раково-эмбриональный антиген
- мониторинг течения и лечения рака прямой кишки;
- мониторинг опухолей желудочно-кишечного тракта, опухолей легких, опухолей молочной железы;
- ранняя диагностика рецидивов и метастазов рака;
- мониторинг в группах риска (цирроз, гепатит, панкреатит).
Альфа–фетопротеин (АФП, AFP)
- для диагностики и мониторинга лечения гепатоцеллюлярного рака;
- для диагностики герминогенных опухолей;
- для диагностики метастазов любой опухоли в печень;
- для скрининга в группе высокого риска (цирроз печени, гепатит).
ХГЧ – хорионический гонадотропин
- для диагностики и мониторинга лечения трофобластических и герминогенных опухолей (применяется в сочетании с тестом определения АФП).
СА-19-9 - карбогидратный антиген 19-9
- для диагностики и мониторинга лечения рака поджелудочной железы;
- для раннего выявления метастазирования опухоли поджелудочной железы;
- для мониторинга рака толстой кишки, желудка, желчного пузыря и желчных протоков.
СА-72-4 – карбогидратный антиген 72-4
- для мониторинга бронхогенного немелкоклеточного рака легкого;
- для мониторинга лечения и контроля течения рака желудка;
- для диагностики рецидивов рака желудка;
- для мониторинга лечения и контроля течения муцинозного рака яичников (в комбинации с лабораторными тестами определения РЭА и СА 125).
СА-125 – карбогидратный антиген 125
- для диагностики рецидивов рака яичника;
- для мониторинга лечения и контроля течения рака яичника;
- для диагностики новообразований родовых путей, брюшины, плевры.
СА-15-3 – карбогидратный антиген 15-3
- для мониторинга лечения и диагностики рецидивов рака молочной железы и легких.
НСЕ (NSE) - нейронспецифическая енолаза
- для диагностики и мониторинга лечения мелкоклеточного рака легкого, нейроэндокринных опухолей;
для диагностики и мониторинга лечения нейробластомы ( в сочетании с РЭА).
SCC – антиген плоскоклеточной карциномы
- для мониторинга течения и эффективности терапии плоскоклеточной карциномы шейки матки.
CYFRA-21-1 – цитокератиновый фрагмент 21-1
- диагностика, мониторинг течения и терапии немелкоклеточного и плоскоклеточного рака легкого;
- наиболее эффективный из всех известных маркеров для мониторинга течения мышечно-инвазивной карциномы мочевого пузыря.
ПСА (PSA) – простатспецифический антиген
- для диагностики и мониторинга лечения рака предстательной железы;
- в качестве диспансерного теста у всех мужчин старше 50 лет.
Для определения уровней онкомаркеров используются следующие автоматические иммуноферментные анализаторы:
Иммуноферментный анализатор Cobas e 411
производства Roche Diagnostics GmbH, Швейцария
Анализы на онкомаркеры
Большинство онкомаркеров производятся и нормальными клетками здорового человека, но в минимальном количестве, а при раке их производство вырастает значительно. Опухолевые маркеры можно обнаружить в крови, моче, кале, самой опухолевой ткани и других тканях, жидкостях из организма больного человека.Сегодня учёным известно множество онкомаркеров, которые изучены и находятся в клиническом использовании. Некоторые из них связаны с одним типом рака, другие — с двумя и более, с отдельными типами онкологии пока не связано никаких опухолевых маркеров.
В современных клиниках онкомаркеры используют для выявления, диагностики и лечения онкологических заболеваний. Однако высокий уровень маркера ещё не показатель, что у человека рак — об этом всегда нужно помнить, когда сдаёте анализы на опухолевые маркеры!
Так, онкомаркер СА 125 используют для выявления онкологии в яичниках. Но этот же маркер повышается и в 1-й триместр беременности, в некоторых других случаях. А тест на простат-специфический антиген (ПСА), который измеряет уровень ПСА в крови, часто используют для скрининга мужчин на наличие рака простаты. Однако повышенный уровень ПСА могут вызывать и доброкачественные состояния простаты — именно такой диагноз получают большинство мужчин с повышенным уровнем ПСА. Потому для постановки диагноза всегда требуется комплексное обследование, другие тесты по необходимости.
Повышенный уровень опухолевого маркера свидетельствует, что в организме происходит какой-то процесс — воспалительный, онкологический, прочие. Потому анализ на онкомаркеры важно и нужно сдавать уже потому, что он — серьёзный сигнал к комплексному медицинскому обследованию.
Опухолевые маркеры — простой и эффективный способ узнать, что здоровье требует вашего пристального внимания.
Показания к проведению анализа
- предрасположенность к онкологии (в семье — онкобольные);
- при подозрении на онкологическое заболевание;
- при плановом, самостоятельном обследовании после 30—40 лет;
- для контроля своего здоровья;
- для отслеживания динамики онкотерапии;
- для оценки результатов онкотерапии.
При плановом или общедиагностическом осмотре женщинам обычно назначают анализы на онкомаркеры, ассоциированные с опухолями яичников и молочных желёз — CA 125 II, CA 15-3, РЭА. Для мужчин стандартный набор опухолевых маркеров составляют ПСА (простат-специфический антиген), РЭА, СА 19-9 (может свидетельствовать об онкологическом процессе в поджелудочной железе, прямой и сигмовидной кишке).
Главные онкомаркеры, применяемые в международной клинической практике
PCA (ПСА)
Простат-специфический антиген (ПСА) — наиболее важный опухолевый маркер рака предстательной железы. Однако и у него есть диагностические пределы. Например, при доброкачественной гиперплазии предстательной железы также повышается уровень ПСА, что даёт при исследовании ложноположительные результаты. А у некоторых мужчин с позже диагностированным раком предстательной железы ПСА в сыворотке крови демонстрирует ложноотрицательный результат. Высокую чувствительность маркер проявляет при мониторинге пациента после терапии рака. При всём этом информативность теста на уровень ПСА — одна из самых высоких среди опухолевых маркеров. Потому его активно назначают и используют в диагностировании, лечении.Для проведения теста используют кровь из вены. Результаты готовы обычно через 24 часа или ранее.
Кому и для чего назначают тест на ПСА:
- при мониторинге терапии рака простаты, для оценки эффективности проведённой терапии (1 раз в 3—4 месяца);
- при подозрении на онкологию простаты, которое возникло во время других исследований (пальцевого исследования или УЗИ);
- при профилактическом обследовании мужчин, которые старше 40 лет.
Подготовка к тестированию на ПСА:
- за 8 часов до тестирования не принимать пищу, исключить алкоголь, кофе, чай, соки.
Важно! В разных лабораториях условия относительно приёма пищи могут различаться, потому обязательно узнайте у врача или специалиста-лаборанта, что можно/нельзя есть, пить перед тестированием.
- примерно за неделю до теста — отказаться от половых контактов, езды на велосипеде, лошади (возможен ложноположительный результат);
- за 30 минут до сдачи крови — не курить;
- сдавать тест до осмотра урологом (если планируете) или примерно через 2 недели после осмотра;
- если были проведены УЗИ, массаж простаты, любые другие физические воздействия на простату, мочевой пузырь, то сдавать кровь для теста нужно не ранее, чем через 14 дней, иначе возможен ложноположительный результат;
- если проведена биопсия простаты, тест проводят минимум через 30 дней после.
СА 125
СА 125 — опухолевый маркер, который всегда обнаруживается в эндометрии, брюшине, яичках, перикарде, плевре. Высокая концентрация маркера — сигнал к срочному подробному обследованию на наличие онкологии яичников (в большинстве случаев), а также поджелудочной железы, молочных желёз, лёгких, толстой кишки, эндометрия).
Тест на СА 125 назначают в первую очередь женщинам, среди родственниц которых были заболевшие раком яичников. Анализ необходим и при подозрении на онкологию, чтобы рассматривать его результаты комплексно с другими исследованиями.
Чаще всего исследование назначают:
- перед терапией рака, чтобы вести мониторинг лечения;
- при уже поставленном диагнозе рака;
- после терапии рака — для оценки результатов.
Важно! Тест на СА 125 не используют для постановки диагноза «рак яичников», потому что врачи наблюдают множество доброкачественных процессов, при которых уровень онкомаркера оказывается повышенным.
Подготовка к исследованию
- До взятия крови необходимо не курить 30 минут.
Расшифровка результатов
Нормой считается содержание СА 125 в крови на уровне 0—35 Ед/мл.
Действительно эффективным тестирование на концентрацию СА 125 в крови является при лечении рака.
- Если во время терапии уровень СА 125 снижается, лечение проходит эффективно.
- Если остаётся высоким или ещё растёт — терапия не даёт результата.
- Если исследование после лечения показывает, что СА 125 снова увеличивается в крови, возник рецидив рака.
СА 15-3
Опухолевый маркер СА 15-3 вырабатывают здоровые клетки молочных желёз. Повышение уровня антигена — свидетельство определённых процессов в организме. Так, СА 15-3 повышается примерно у 10 % женщин с онкологией молочной железы на ранней стадии. Потому для скрининга рака тест на СА 15-3 используют лишь в сочетании с другими исследованиями.
Важно! Диагностическая точность теста на уровень СА 13-5 увеличивается при одновременном тестировании на уровень онкомаркера РЭА.
Значительно чувствительнее и информативнее определение СА 13-5 при диагностировании метастазов рака. В среднем у 70 % женщин с метастазами уровень опухолевого маркера оказывается высоким и растёт. Высокий уровень СА 13-5 может наблюдаться и при раке эндометрия, яичников, лёгких, колоректальном раке, при доброкачественных образованиях в молочных железах, при беременности, гепатите и т. д.
Нормой СА 13-5 считают показатель 0—25 Ед/мл.
Важно! Ни в коем случае нельзя интерпретировать самостоятельно результаты тестирования ни в положительную, ни в отрицательную сторону. На ранней стадии до 40 % опухолей молочной железы не продуцируют СА 13-5. Ложноположительные результаты также могут возникать при аутоиммунных заболеваниях, саркоидозе, туберкулёзе.
Раковый эмбриональный антиген (РЭА) в норме вырабатывается в небольших количествах некоторыми здоровыми клетками. Во внутриутробном развитии РЭА стимулирует размножение клеток (откуда и название антигена), о предназначении в организме взрослых людей медики и учёные пока не знают. Повышение уровня РЭА может свидетельствовать об онкологических процессах в прямой и толстой кишке. При раковых заболеваниях концентрация РЭА увеличивается многократно.
Важно! Повышение уровня РЭА происходит и при развитии доброкачественных опухолей, при аутоиммунных, воспалительных и некоторых других заболеваниях, при регулярном курении, употреблении алкогольсодержащих продуктов. Потому онкомаркер РЭА для скрининга рака самостоятельно не используется — только в комплексе с другими тестами и исследованиями.
Повышение РЭА наблюдается также при онкологии яичников, простаты, лёгких, молочных желёз, поджелудочной железы, желудка.
Норма содержания РЭА в крови:
- 0—3,8 нг/мл — для тех, кто не курит;
- 0—5,5 нг/мл — для тех, кто курит.
Важно! Методики определения РЭА в разных лабораториях различаются. По этой причине мониторинг уровня опухолевого маркера нужно делать в одной лаборатории, чтобы правильно отслеживать динамику его повышения/понижения/покоя.
СА 19-9
СА 19-9 продуцируется эпителием ЖКТ. Его нормальный уровень начинается изменяться — стабильно расти — при развитии опухолей в ЖКТ. Особенно выразительна эта взаимосвязь при онкологии поджелудочной железы — примерно у 70 % людей с таким диагнозом уровень СА 19-9 высокий.
Но тестирование на СА 19-9 также не может использоваться самостоятельно для диагностики рака желудка или поджелудочной. Повышение уровня этого онкомаркера наблюдается при раке яичников, желчного пузыря, печени, желудка, колоректальном, при циррозе печени и гепатитах, панкреатите, желчнокаменной болезни и других патологиях.
Норма для СА 19-9 — 0—34 Ед/мл.
Важно! Нормальный уровень СА 19-9 не гарантирует, что у человека нет рака поджелудочной железы. При наличии соответствующих симптомов необходимо продолжить обследование, чтобы убедиться в диагнозе.
АФП (альфа-фетопротеин)
Альфа-фетопротеин вырабатывается в эмбрионе человека, транспортирует вещества, необходимые для развития плода, защищает от иммунитета матери. В организме взрослого АФП присутствует в чрезвычайно малом количестве или полностью отсутствует. Его умеренное повышение бывает связано с патологиями печени, акушерскими патологиями. Значительное повышение может свидетельствовать о низкодифференцированной опухоли, чаще всего — раке половых желёз или печени.
Эритропротеин (ЕРО)
Эритропротеин — гормон почек, регулирующий кислородный обмен в организме. Он стимулирует в костном мозге выработку эритроцитов, которые попадают в кровяное русло и переносят кислород. Тестирование на уровень ЕРО назначают пациентам с анемией, с хронической почечной недостаточностью и некоторыми другими заболеваниями.
В норме содержание ЕРО в крови — 4,3—29 мМе/мл. Повышение уровня с одновременным снижением количества эритроцитов может свидетельствовать о нарушении функциональности костного мозга. Другие изменения комбинации «ЕРО—эритроциты» бывают вызваны нарушением работы почек, железодефицитными анемиями, апластическими и гемолитическими анемиями, онкологическими заболеваниями костного мозга, заболеваниями лёгких, беременностью, химиотерапией, кистами почек, аденокарциномой почки, опухолью мозжечка и других органов — доброкачественными и злокачественными.
Постановка диагноза по результатам теста на уровень ЕРО объективно невозможна. Но этот тест играет важную роль в диагностировании совместно с другими исследованиями.
Общие правила для сдачи анализов
Все анализы на онкомаркеры проводятся на крови из вены, которую сдают утром, натощак.
Особые рекомендации мы привели выше. Напомним:
- перед сдачей крови нельзя курить в течение получаса;
- перед исследованием необходимо точно узнать правила подготовки в той лаборатории, где вы будете сдавать анализы.
Стоимость анализов на онкомаркеры в АО "СЗДЦМ"
В медицинских центрах и лабораторных терминалах АО "СЗДЦМ" вы сможете пройти тестирование на все основные онкомаркеры и получить достоверные результаты.
Читайте также:
